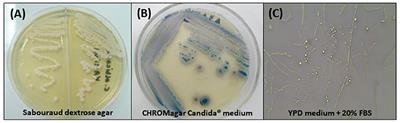

Candida tropicalis Clearance
Candida tropicalis Clearance, Yeast infection contagious in bath, sputum sample with candida tropicalis Clearance
SKU: 7dd4332f

Buy now.
Pay later.
Earn rewards
Representative APR: 29.9% (variable)
Credit subject to status. Terms apply.
Missed payments may affect your credit score
FrasersPlus
Available Products